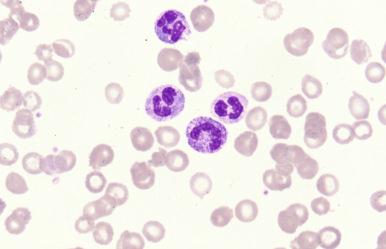
Figure 12-1, Toxic granulation and vacuolization in peripheral blood neutrophils due to infection.

Physical Address
304 North Cardinal St.
Dorchester Center, MA 02124
This chapter addresses the peripheral blood and bone marrow response to a variety of non-malignant conditions. A bone marrow examination may be performed to evaluate a fever of unknown origin, looking for a specific infectious cause. In inflammatory or metabolic disorders, the bone marrow findings may be consistent with the underlying disease, suggestive of a complication of the disease, or related to treatment.
Reactive leukocytic proliferations and their associated differential diagnoses are discussed first, followed by specific findings in infectious, inflammatory, and metabolic disorders.
Neutrophilic hyperplasia is usually caused by the endogenous secretion of granulocyte-macrophage colony-stimulating factor or granulocyte colony-stimulating factor in response to inflammation. Common causes are infection, collagen vascular disease, and malignancy ( Box 12-1 ). Demargination of neutrophils into the circulating pool, and subsequent doubling of the neutrophil count, can be seen after acute stress or epinephrine administration. Corticosteroid therapy increases neutrophils in the peripheral blood due to their early release from marrow stores. Exogenous growth factor therapy may also cause a rise in the neutrophil count. It may be difficult in some cases to distinguish between reactive neutrophilic hyperplasia and a myeloproliferative process (typically chronic myeloid leukemia). Morphologic findings such as a basophilia, abnormal megakaryocytes, and marrow fibrosis may be helpful, but genetic analysis is often needed to determine the diagnosis.
Infection
Autoimmune disorders
Collagen vascular disease
Malignancy
Exogenous growth factor therapy (granulocyte-macrophage colony-stimulating factor, granulocyte colony-stimulating factor)
Acute stress
Obesity
Drugs
Epinephrine administration
Corticosteroid therapy
Lithium
Smoking
Obesity
In reactive neutrophilia, examination of the peripheral blood smear shows an increase in the absolute neutrophil count. The white blood count rarely exceeds 50 × 10 9 /L. Circulating immature neutrophils, termed a left shift, are often present, and morphologic abnormalities such as toxic granulation, cytoplasmic vacuolization, and Döhle bodies are seen ( Fig. 12-1 ). Marrow aspirate smears show an increased myeloid-to-erythroid ratio and, in some cases, a relative increase in myelocytes and promyelocytes. Increased cytoplasmic granularity may be noted. Marrow tissue sections may show increased cellularity, with an increased myeloid-to-erythroid ratio. Early granulocytic precursors are typically seen in peritrabecular areas. In some cases, this proliferation is so exuberant that it is mistaken for a neoplastic process and can even mimic metastatic carcinoma ( Fig. 12-2 ).

An increase in lymphoid cells in the peripheral blood is associated with a variety of underlying conditions, most commonly related to viral infections (Epstein-Barr virus [EBV], cytomegalovirus [CMV], hepatitis, human herpesvirus 6, human immunodeficiency virus [HIV]) or drug reactions (particularly phenytoin), but it may also be seen in “stress” conditions. The latter conditions may be related to endogenous epinephrine release. Rare cases of polyclonal T-cell lymphocytosis have been described in patients with thymomas. The peripheral lymphocytosis secondary to infection is predominantly a T-cell reaction. An increase in large granular lymphocytes may be seen after bone marrow transplantation.
Reactive marrow lymphocytosis is characterized by an increase in benign-appearing lymphocytes. The increase may or may not be associated with a peripheral lymphocytosis and may be due to either an interstitial increase in lymphoid cells or an increase in lymphoid aggregates. Increased precursor B-lymphoid cells (hematogones) may be seen in a variety of conditions, especially in children, but they are common after chemotherapy in both adults and children ( Fig. 12-3 ). These cells are often difficult to distinguish from lymphoblasts in acute lymphoblastic leukemia (see Chapter 42 ). The patient's age is important in determining whether lymphoid cells are increased because children normally have more lymphocytes (up to 35%) in the bone marrow. In adults, the normal value for lymphocytes on the aspirate smear is approximately 6% to 25%.

Persistent polyclonal B-cell lymphocytosis is a rare disorder seen primarily in young women who are often cigarette smokers ( Box 12-2 ). Patients are typically asymptomatic and rarely have lymphadenopathy or splenomegaly. There is an association with human leukocyte antigen-DR7 (HLA-DR7). EBV has been found in the peripheral blood cells of some patients, and the cells appear to have a defective CD40 activation pathway. Increased polyclonal immunoglobulin M (IgM) is found in the serum.
Female predominance
Age 20 to 40 years
Asymptomatic
Cigarette smoker
Peripheral lymphocytosis
Bilobed lymphocytes
Increase in polyclonal serum immunoglobulin M
Multiple BCL2/IGH gene rearrangements
Epstein-Barr virus in peripheral blood
Polyclonal immunophenotype—memory B cells
Increased frequency of HLA-DR7
Isochromosome i(3q)
The peripheral blood shows increased lymphocytes with moderate amounts of cytoplasm and bilobed nuclei ( Fig. 12-4 ). These cells may be seen in the bone marrow aspirate smear and biopsy, typically in an intrasinusoidal or intravascular pattern. Immunophenotypic evaluation shows a polyclonal proliferation of B cells that are often IgD + and CD27 + ; multiple BCL2/Ig rearrangements have been detected. Isochromosome i(3q) and trisomy 3 are present in some cases. The lymphoid proliferation may persist for many years without any clinical evidence of the development of malignancy.

Reactive eosinophilia is caused by a wide variety of underlying conditions ( Box 12-3 ). Mild elevations in the eosinophil count are usually due to allergic conditions; moderate eosinophilia is more common in lymphomas, rheumatoid arthritis, and non-hematologic malignancies; and severe elevations are seen in parasitic infections, pulmonary eosinophilia, and clonal eosinophilic disorders. Rarely, reactive eosinophilia has been reported as a constitutional abnormality; two of the reported patients had a chromosomal abnormality—a pericentric inversion of chromosome 10.
Atopic disorders: allergy, asthma, eczema
Parasitic infections: Toxocara canis most common in the United States
Autoimmune disease
Drug reactions
Hematopoietic growth factor and interleukin-3 therapy
Inflammatory skin disorders
Carcinoma
T-cell malignancies
Acute lymphoblastic leukemia with t(5;14)(q31;q32)
Mycosis fungoides
Peripheral T-cell lymphoma
B-cell lymphomas
Hodgkin's lymphoma
Pulmonary eosinophilic syndromes
Transplant rejection
Vasculitis
Constitutional abnormality
In cases of reactive eosinophilia, the marrow aspirate smears show increased eosinophils and precursors, usually greater than 5% of the bone marrow nucleated cells. Eosinophilic myelocytes frequently show small basophilic granules. Such myelocytes represent a normal stage of eosinophil development, and the basophilic granules likely represent eosinophil primary granules. In tissue sections of the bone marrow, there is often a diffuse increase in eosinophils and precursors, but focal eosinophilia may be seen surrounding the lesions of marrow involvement by Hodgkin's lymphoma, malignant lymphoma, benign lymphoid aggregates, systemic mast cell disease, and Langerhans histiocytosis ( Fig. 12-5 ). In these cases, increased eosinophils may not be seen in the peripheral blood or in the aspirate smear.

A more detailed discussion of the evaluation of patients with non-neoplastic and neoplastic eosinophilia can be found in Chapter 50 .
Reactive basophilia is not a common finding. In some cases, it may be seen with a reactive eosinophil proliferation. Peripheral blood findings show an absolute basophil count greater than 0.2 × 10 9 /L. Bone marrow aspirate smears show an increase in basophils and precursors, accounting for more than 2% of cells.
Commonly associated conditions are allergies, carcinoma, chronic inflammation, malignant lymphoma, plasma cell myeloma, radiation, and renal failure.
A peripheral blood monocytosis is defined as a monocyte count greater than 1 × 10 9 /L; an increased monocyte level in a bone marrow aspirate smear is often defined as greater than 3% of the differential count. Associated conditions include acute and chronic inflammation, autoimmune disorders, acute myocardial infarction, carcinoma, hypothyroidism, and splenectomy ( Box 12-4 ). Monocytes are also commonly increased in the presence of neutropenia after chemotherapy or due to a congenital deficiency.
Acute and chronic inflammation
Acute myocardial infarction
Autoimmune disorders
Carcinoma
Hodgkin's lymphoma
Hypothyroidism
Neutropenia
Splenectomy
Bacterial infections often cause an increase in neutrophils in the peripheral blood, with an increase in immature myeloid cells, or a left shift. Exceptions are seen in neonates and in older adult or debilitated patients who cannot mount a neutrophilic response. Morphologic changes associated with bacterial infection include toxic granulation, Döhle bodies, and cytoplasmic vacuolization. In rare cases, bacteria may be seen within neutrophils and monocytes. An increase in circulating neutrophils results in a subsequent increase in myeloid precursors in the bone marrow.
Rare bacterial infections such as pertussis may cause a lymphocytosis in the peripheral blood, which consists of predominantly CD4 + cells ( Fig. 12-6 ). In children, these lymphocytes often have clefted, irregular nuclei, similar to the cells seen in peripheralization of follicular lymphoma. Neutropenia may be seen with Salmonella or Brucella infections. Uncomplicated tuberculosis infection does not typically cause a change in the neutrophil count.

Red cell abnormalities are rarely seen in bacterial infections. Mycoplasma pneumonia can lead to the development of a cold agglutinin. Severe hemolysis can be seen in Clostridium infection owing to the presence of a hemolysin, phospholipase C.
The only bacterial infections diagnosed with any frequency within the bone marrow are those due to mycobacteria (see later). Rare cases of infection with Tropheryma whippelii, the causative agent of Whipple's disease, have been described. Periodic acid–Schiff–positive organisms are seen within marrow macrophages. Confirmation can be accomplished by polymerase chain reaction or electron microscopy. Salmonella typhi infection has been associated with pancytopenia due to hemophagocytosis, granulomas, ring granulomas, or bone marrow necrosis. Salmonella organisms may be seen within neutrophils and monocytes. Bone marrow involvement by lepromatous leprosy is characterized by a proliferation of foamy histiocytes that contain the bacilli or by the presence of bacilli lying free in the marrow interstitium. Brucellosis can cause marrow granulomas, hemophagocytosis, and peripheral pancytopenia ( Fig. 12-7 ).

Mycobacterial infection of the bone marrow is most commonly caused by Mycobacterium tuberculosis or Mycobacterium avium complex. Rare cases of infection with other mycobacteria have been described. Patients with pulmonary tuberculosis may have thrombocytosis, leukocytosis, or monocytosis. Peripheral blood abnormalities in miliary tuberculosis include the anemia of chronic inflammation, leukopenia, thrombocytopenia, and pancytopenia. Peripheral lymphopenia or thrombocytopenia suggests marrow involvement by granulomas in M. tuberculosis . Patients with M. avium complex infection often have peripheral blood abnormalities associated with an underlying HIV infection. Negatively stained linear inclusions may be seen within histiocytes on Wright-stained preparations in M. avium complex infection ( Fig. 12-8, A and B ). Granulomas can rarely be found on an aspirate smear but are typically detected on the clot section or core biopsy. Caseation within marrow granulomas is rare, but when present it is highly suggestive of infection with M. tuberculosis . In M. avium complex infection, the granulomas may not be well formed, or there may be diffuse infiltration by histiocytes. Special stains for acid-fast bacilli show rare organisms in M. tuberculosis (see Fig. 12-8, C ); the bacilli are more easily found in cases of M. avium complex infection and may be numerous. Blood cultures are a more sensitive technique for detecting mycobacteria, especially in the setting of HIV infection, and it has been argued that bone marrow examination has limited value in this setting. Detecting the organism with an acid-fast bacilli stain can significantly shorten the time it takes to make a diagnosis, which may have a positive clinical impact. Rarely, granulomas and organisms can be found in culture-negative patients.

Rickettsial infections, including Q fever, ehrlichiosis, and anaplasmosis have been diagnosed in the bone marrow and blood. Infection with Coxiella burnetii causes Q fever, which leads to a characteristic donut or ring granuloma in bone marrow clot sections or core biopsies. The granuloma consists of a ring of epithelioid histiocytes and neutrophils surrounding a central vacuole with an outer fibrin ring ( Fig. 12-9 ). These granulomas are not specific for Q fever and have been seen in CMV infections as well as Hodgkin's lymphoma, EBV infection, and typhoid fever.

Human ehrlichiosis and anaplasmosis are caused by infection with Ehrlichia chaffeensis, Anaplasma phagocytophilum, or, less commonly, Ehrlichia ewingii . The first organism infects monocytes, and the other two infect granulocytes. Any of these infections can cause leukopenia, with a left shift, and thrombocytopenia. Fever and elevated hepatic transaminases may also be seen. The organisms can be identified in the peripheral blood smear, in which small clusters of darkly stained bacteria may be found rarely in monocytes or more commonly in neutrophils. Bone marrow pathology has been better studied in monocytic ehrlichiosis. Granulocytic hyperplasia is common; organisms may be seen within histiocytes in the aspirate, and 67% of patients have granulomas on biopsy sections ( Fig. 12-10 ). The bone marrow in patients infected with Anaplasma is either normocellular or hypercellular, with rare infected cells present. Lymphoid aggregates, plasmacytosis, and erythrophagocytosis may be seen. Polymerase chain reaction testing of peripheral blood can confirm the diagnosis.

Infections with tissue-invasive parasites result in an increased eosinophil count in the peripheral blood and bone marrow. Toxoplasma gondii pseudocysts have been seen in association with bone marrow necrosis in patients with acquired immunodeficiency syndrome (AIDS). Leishman-Donovan bodies can be seen with macrophages in patients with leishmaniasis. Leishmaniasis is a severe disease caused by Leishmania species found in endemic areas, but it is also an opportunistic infection in immunocompromised individuals, including those with HIV infection or bone marrow transplantation. Clinical findings include fever, hepatosplenomegaly, and pancytopenia. A reactive increase in plasma cells is seen on the aspirate smear. Granulomas may be seen on the core biopsy or clot section. The amastigotes are typically visible within histiocytes. The cytoplasm of the amastigote stains blue, with a red nucleus and a rod-shaped kinetoplast.
Become a Clinical Tree membership for Full access and enjoy Unlimited articles
If you are a member. Log in here